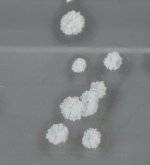
IMG_100013.jpg IMG_100013.jpg

Hi Folks,
My first try was with 50g of Acacia Acuminata root bark; I did a cold extraction with heptane using 24-hour soaks at each stage, only doing one pull and got 176mg.
This is what I followed
This time, I followed the same process but used a heat bath and naphtha (Shellite). I performed three heated extractions and three pulls with naphtha. I also washed the naphtha pulls in water. I was excited because I thought all the extra effort would produce a win. This morning, I checked my results, and they were even worse, at a measly 128mg.
I have some questions.
Can the bath temperature be too high? I bought a cheap electric heater, and its lowest temperature is 60 degrees. The water never got to a bubble simmer heat but was very warm to the touch. I would say it was probably 60 degrees. Is there an optimal temperature? Should I have had it lower or higher?
Is heptane a better fuel? Should I stick with that? My results last time were cleaner looking. I'm in Australia and heard that the Naptha sold here isn't as good as it used to be (I'm using Diggers Shellite)
My bark and vinegar pH was 3, maybe 4; when I added salt and NaOH, it went to 14. Are these correct?
Is there a better tek I should follow for this kind of bark?
I really appreciate any help you can provide.
Thanks!
My first try was with 50g of Acacia Acuminata root bark; I did a cold extraction with heptane using 24-hour soaks at each stage, only doing one pull and got 176mg.
This is what I followed
This time, I followed the same process but used a heat bath and naphtha (Shellite). I performed three heated extractions and three pulls with naphtha. I also washed the naphtha pulls in water. I was excited because I thought all the extra effort would produce a win. This morning, I checked my results, and they were even worse, at a measly 128mg.
I have some questions.
Can the bath temperature be too high? I bought a cheap electric heater, and its lowest temperature is 60 degrees. The water never got to a bubble simmer heat but was very warm to the touch. I would say it was probably 60 degrees. Is there an optimal temperature? Should I have had it lower or higher?
Is heptane a better fuel? Should I stick with that? My results last time were cleaner looking. I'm in Australia and heard that the Naptha sold here isn't as good as it used to be (I'm using Diggers Shellite)
My bark and vinegar pH was 3, maybe 4; when I added salt and NaOH, it went to 14. Are these correct?
Is there a better tek I should follow for this kind of bark?
I really appreciate any help you can provide.
Thanks!
Last edited: